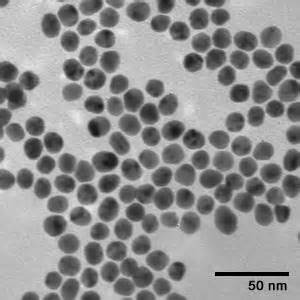
Dextran modified Gold Nanoparticles

Home > products > gold-nanoparticles
> biological-coating-gold-nanoparticle
> dextran-modified-gold-nanoparticles
Dextran modified Gold Nanoparticles
 Dextran modified Gold Nanoparticles,cas7440-57-5
Dextran modified Gold Nanoparticles,cas7440-57-5
| Catalog # | Pkg Size | Price(USD) | Quantity | Buy this product |
|---|---|---|---|---|
| R-GD01505-X | 25ml | 550.00 | + Add to cart |
|
| R-GD01505-X | 50ml | 780.00 | + Add to cart |
|
|
||||
Product description
Dextran coating gold nanoparticles have better steric stability, also could enhance its permeability to easily gathering at tumor tissue.
| Appearance | Wine-red solution |
|---|---|
| Dextran Molecular Weight | 4k;10k;20k;40k;70k |
| Dispersant | H2O |
| Concentration | 50μg/ml |
| Storage | 2-8℃ |
| Stability | 6 months |
Document
Related Product

 Items-$0.00
Items-$0.00

 Email:
Email: Tel.:
Tel.: RuixiBiotechCo.Ltd /KamulinBiotechco.ltd
RuixiBiotechCo.Ltd /KamulinBiotechco.ltd
 Add: Room 20F 2002, Meiyuan Building, Yanta District, Xi’ an City, Shaanxi Province 710061 China
Add: Room 20F 2002, Meiyuan Building, Yanta District, Xi’ an City, Shaanxi Province 710061 China
 Tel: 02988811435
Tel: 02988811435
 Fax: (86-29)8881-1435
Fax: (86-29)8881-1435
 Email: sales@ruixibiotech.com
Email: sales@ruixibiotech.com
 Web: http://www.ruixibiotech.com
Web: http://www.ruixibiotech.com


